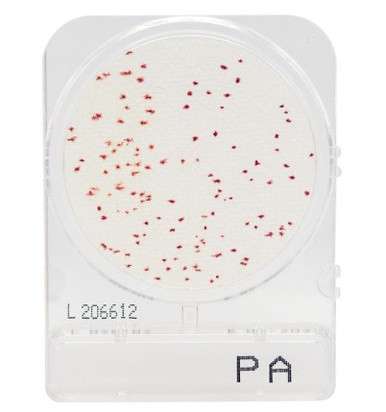
CompactDry™ Pseudomonas Aeruginosa (PA), 100-pk - Ibis Scientific, LLC

マイストア
変更
お店で受け取る
(送料無料)
配送する
納期目安:
2025.12.26 14:26頃のお届け予定です。
決済方法が、クレジット、代金引換の場合に限ります。その他の決済方法の場合はこちらをご確認ください。
※土・日・祝日の注文の場合や在庫状況によって、商品のお届けにお時間をいただく場合がございます。
P.Bacteria spore バクテリア タイ輸入 極大サイズ ビカクシダP.willinckii Bacteria spore 極大サイズの詳細情報
極大サイズ ビカクシダP.willinckii Bacteria spore 極大サイズ。P.willinckii 'Bacteria' spored バクテリア。P.willinckii 'Bacteria' spored バクテリア。タイから輸入したビカクシダです。小さくまとまりながらも分岐が美しいです。第四種郵便で発送します。+300円で速達をお付けしますので、お申し付けください。植物ですので、状態は変わっていきます。ご了承ください。即購入可能です。よろしくお願いします!。Health Hazard Associated with the Presence of Clostridium Bacteria。ビカクシダ P.FSQ VP#11 pup。motimoti 様Totoro sporeling special。ビカクシダウィリンキーエネル 子株。【こたつ】速達。★希少★ アロカシア サリアン 斑入り 鉢のまま発送。蘇鉄
ベストセラーランキングです
近くの売り場の商品
カスタマーレビュー
オススメ度 4.5点
現在、5385件のレビューが投稿されています。